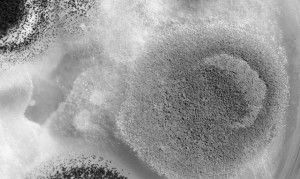

Грибковий або кандидозний стоматит у дитини - це часте явище. Зовні його неможливо переплутати з іншим захворюванням, так як для молочниці в роті характерний білуватий наліт, які легко зчищається.
Захворювання вимагає лікування, в іншому випадку існує ризик посилення симптомів.
Причини зараження дитини
Збудником грибкового стоматиту є дріжджоподібні гриби виду Кандида. Вони завжди
присутні в мікрофлорі слизових людини, і в нормальному стані не завдають ніякого дискомфорту. При зміні мікрофлори ротової порожнини і дисбактеріозі відбувається стрімке зростання популяції грибків, в результаті на слизовій з'являється білий наліт, що супроводжується свербінням і палінням.
Грибковий стоматит розвивається у дітей будь-якого віку, особливо йому схильні немовлята, чия мікрофлора ще повністю не сформувалася. Серед причин розвитку кандидозного стоматиту:

- ослаблений імунітет,
- штучне годування,
- медикаментозне лікування,
- зараження від матері.
У дітей старшого віку кандидозний стоматит часто розвивається на тлі носіння брекет-систем для вирівнювання прикусу. Ще одна популярна причина стрімкого зростання грибків - це зловживання солодким.
Розвиток кандидозного стоматиту може бути спровоковано звичкою дитини тягнути все в рот, вживанням немитих фруктів, а також порушенням особистої гігієни порожнини рота.
Дорослі люблять цілувати і обіймати новонародженого, не знаючи, що таким чином можуть завдати шкоди його здоров'ю. Склад дитинкою мікрофлори ротової порожнини значно відрізняється від дорослої. Будь-яке найменше порушення призводить до розвитку грибкового стоматиту.
При поцілунках дорослих, разом зі слиною, дитині передається частина дорослого мікрофлори, яка порушує крихку мікрофлору дитячого організму.
Особливо важливо уникати поцілунків бабусь і дідусів малюка, які носять зубні протези. Під протезами часто накопичуються бактерії, що призводять до дисбалансу мікрофлори ротової порожнини і стрімкого зростання грибків. В результаті дорослий, сам того не знаючи, може заразити дитину грибкових стоматитом.
симптоми захворювання
Для будь-якого грибкового захворювання характерний тривалий перебіг. Як правило, на початковому етапі зараження відсутні яскраво виражені симптоми, а діагностувати грибковий стоматит
- набряк і чутливість слизової оболонки рота,
- білястий густий наліт на зворотному боці щік, на язику і на небі,
- відчуття печіння,
- втрата апетиту.
Наліт легко можна зняти, однак після цього можливе легке кровотеча і хворобливість. Протягом декількох годин на очищеному місці знову утворюється наліт.
можливі ускладнення
Грибковий стоматит ротової порожнини вимагає своєчасного лікування, в іншому випадку можливе ураження гортані і мигдалин і, як наслідок, болючість при спробі зробити ковток. З плином часу можлива поява тріщин і заїду в куточках губ, припухлість мови і посилення неприємних відчуттів. Поширення грибкової інфекції може досягти внутрішніх органів, а в цьому випадку лікування буде тяжким і тривалим.
Як правило, для кандидозного стоматиту не характерно підвищення температури.
Годує грудьми мама може заразитися грибковою інфекцією від малюка. При цьому виникає хворобливість під час годування і лущення шкіри сосків, а також припухлість і біль в молочних залозах.
лікування захворювання
В першу чергу необхідно відвідати дитячого лікаря, який точно поставить діагноз і призначить необхідне лікування.

Також лікар може призначить спеціальний крем з клотримазолом для обробки ротової порожнини.
Дітям старшого віку показані регулярні полоскання антимикотическим розчином і антисептичними засобами для зменшення ризику занесення інфекції. У домашніх умовах часто використовуються содові аплікації і водно-содовий розчин для полоскання рота. У разі сильної грибкової інфекції, можуть застосовуватися спеціальні препарати у вигляді таблеток, але тільки за призначенням лікаря.
Також лікування включає заходи щодо поліпшення імунітету, тому лікар може призначити прийом вітамінно-мінеральних комплексів, прибутків або імуномодуляторів. Якщо захворювання викликане порушенням мікрофлори внаслідок неправильного харчування, дитині показана дієта, що виключає солодке, солоне і гостре.
Якщо у малюка виявлено стоматит кандидозний або грибковий, дорослі члени сім'ї також повинні пройти лікування, щоб випадково при поцілунку не заразити дитину повторно.
Лікування дорослих проводитися тими ж препаратами, який приймає дитина, але тільки у відповідному дозуванні.
профілактичні заходи

Грибкова інфекція може передатися дитині від матері під час пологів, тому дуже важливо ретельно стежити за власним здоров'ям в останні місяці виношування дитини і при необхідності обов'язково пройти курс лікування вагінального кандидозу до пологів.
Важливим етапом є стерилізація пустушок і пляшечок. Мати ні в якому разі не повинна брати дитячу соску в рот. При контакті зі слиною дорослих може порушитися тендітна мікрофлора ротової порожнини новонародженого, в результаті розвивається грибковий стоматит.
Для профілактики грибкового стоматиту у дітей старшого віку слід дотримуватися таких правил:
- регулярна гігієна ротової порожнини,
- в разі носіння брекет-систем - обов'язкове ополіскування ротової порожнини після кожного прийому їжі,
- збалансоване харчування,
- в разі хронічних захворювань і зниженого імунітету - обов'язково приймати вітаміни двічі на рік.
Для мінімізації ризику розвитку кандидозного стоматиту у дитини дошкільного віку слід ретельно складати меню і стежити за тим, щоб дитина не зловживав солодким.
- ретельну гігієну ротової порожнини, особливо при носінні протезів,
- своєчасне лікування вагінального кандидозу,
- обов'язкове приймання пробіотиків при проходженні лікування антибіотиками.
Рецидивуючий грибковий стоматит у новонародженого або дитини старшого віку може сигналізувати про серйозні проблеми внутрішніх органів, тому необхідно провести повне обстеження дитини для виявлення причини захворювання.
Знайдіть помилку на сайті і отримаєте 500 рублів!
Виділіть частину тексту з помилкою та натисніть "Ctrl + Enter"
Або скористайтеся цим посиланням.
Детальніше про конкурс.
- Прищі на носі причини у жінок, чому з'являються прищі на носі
- Ендокринне безпліддя: у жінок, чоловіків, причини, діагностика, лікування
- Подошвенная бородавка на стопі
- Ureaplasma urealyticum (уреаплазма уреалітікум): що це, аналіз (виявлена), лікування
- Метронідазол під час місячних: чи можна пити і приймати препарат для лікування